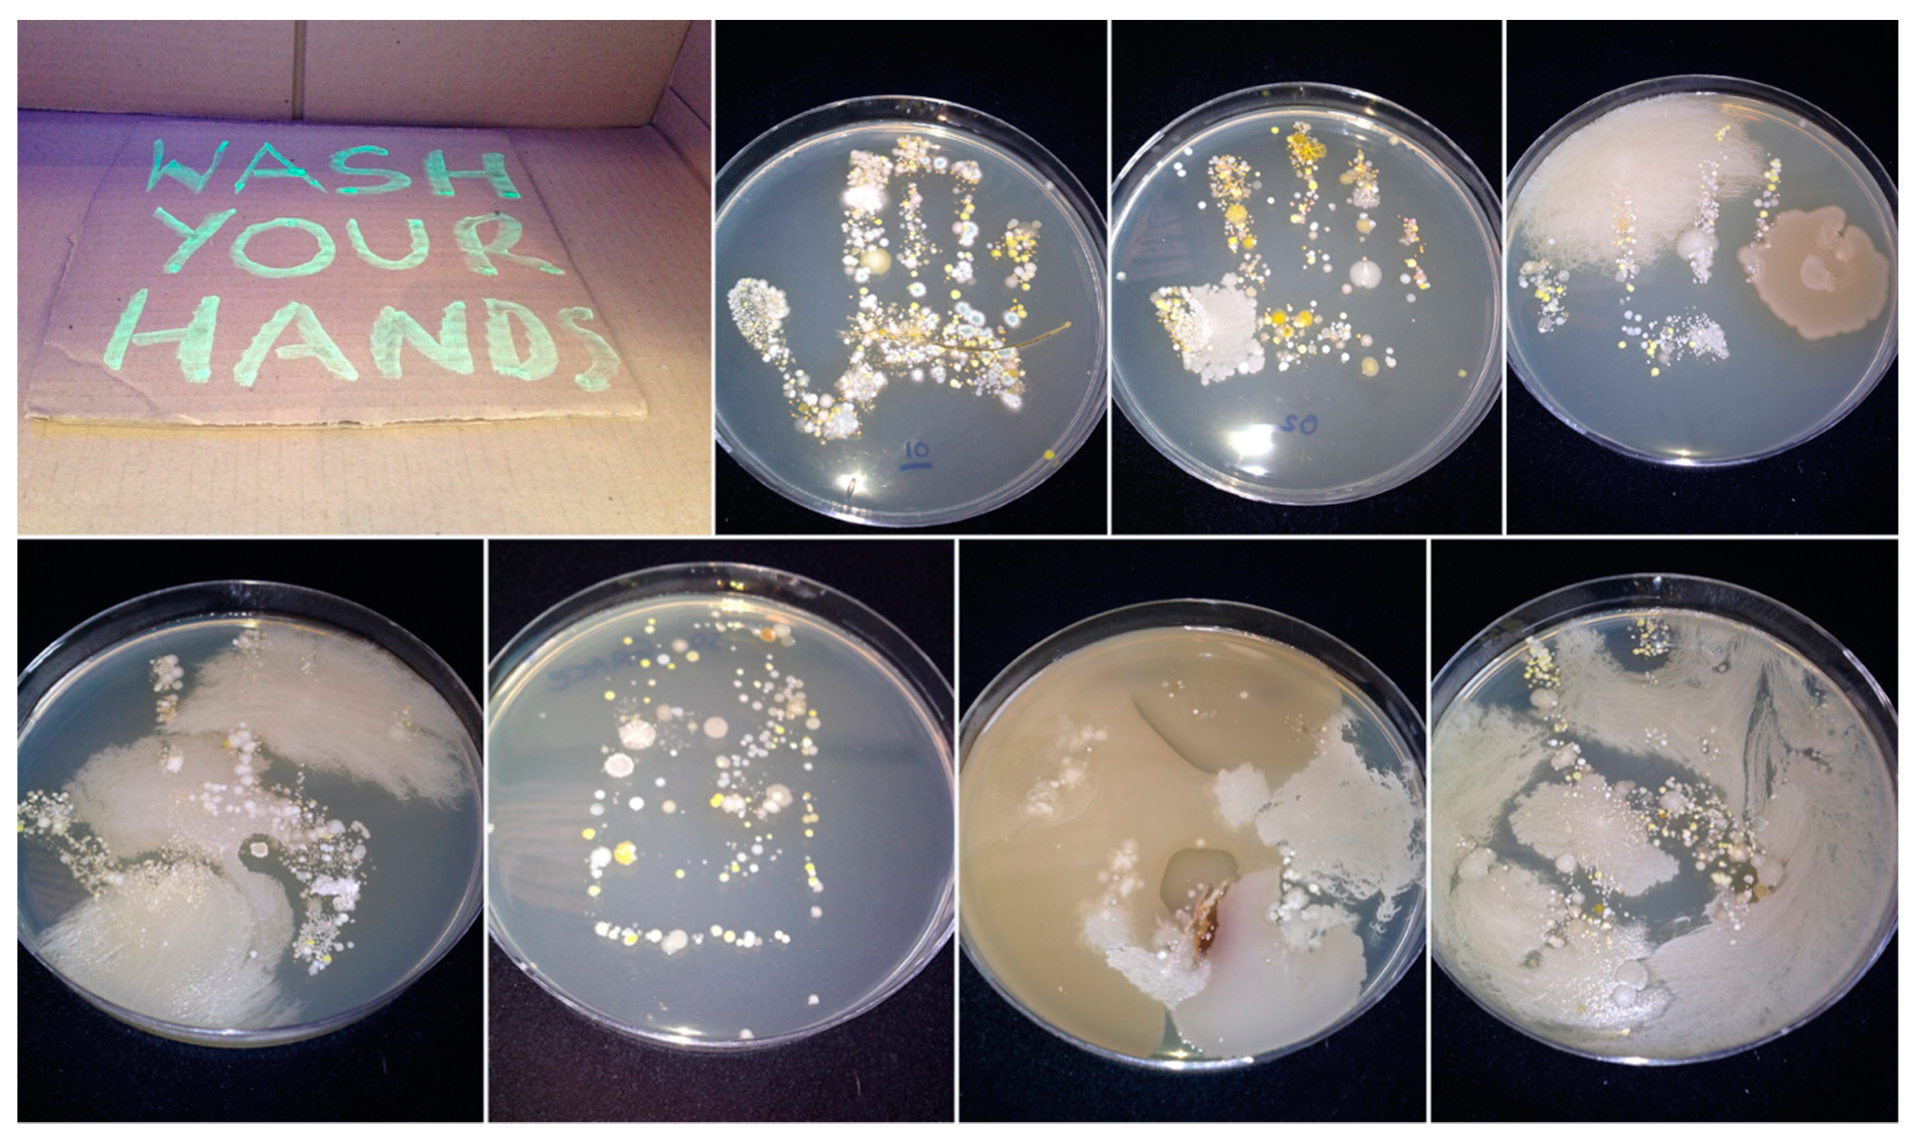
Antibiotics 09 00465 g002

Biofilm Control Strategies: Engaging with the Public
Abstract
1. Introduction
1.1. Activity One: ’Now Wash Your Hands’
1.2. Activity Two: Plaque Attack!
1.3. Activity Three: A Photocatalytic Wall
2. Discussion
3. Conclusions
Author Contributions
Funding
Conflicts of Interest
References
- Timmis, K.; Cavicchioli, R.; Garcia, J.L.; Nogales, B.; Chavarría, M.; Stein, L.; McGenity, T.J.; Webster, N.; Singh, B.K.; Handelsman, J.; et al. The urgent need for microbiology literacy in society. Environ. Microbiol. 2019, 21, 1513–1528. [Google Scholar] [CrossRef] [PubMed]
- Carolan, K.; Verran, J.; Amos, M.; Crossley, M.; Redfern, J.; Whitton, N.; Louttit, D. Simfection: A digital resource for vaccination education. J. Biol. Educ. 2018, 53, 225–234. [Google Scholar] [CrossRef]
- Redfern, J.; Burdass, D.; Verran, J. Practical microbiology in schools: A survey of uk teachers. Trends Microbiol. 2013, 21, 557–559. [Google Scholar] [CrossRef] [PubMed]
- Redfern, J.; Bowater, L.; Coulthwaite, L.; Verran, J. Raising awareness of antimicrobial resistance among the general public in the uk: The role of public engagement activities. JAC-Antimicrob. Resist. 2020, 2, dlaa012. [Google Scholar] [CrossRef]
- Donlan, R.M. Biofilms: Microbial life on surfaces. Emerg. Infect. Dis. 2002, 8, 881–890. [Google Scholar] [CrossRef]
- Allegranzi, B.; Pittet, D. Role of hand hygiene in healthcare-associated infection prevention. J. Hosp. Infect. 2009, 73, 305–315. [Google Scholar] [CrossRef]
- Verran, J. The microbial contamination of mobile communication devices. J. Microbiol. Biol. Educ. 2012, 13, 59–61. [Google Scholar] [CrossRef]
- Verran, J.; Haigh, C.; Brooks, J.; Butler, J.A.; Redfern, J. Fitting the message to the location: Engaging adults with antimicrobial resistance in a world war 2 air raid shelter. J. Appl. Microbiol. 2018, 125, 1008–1016. [Google Scholar] [CrossRef]
- Redfern, J.; Bowater, L.; Crossley, M.; Verran, J. Spreading the message of antimicrobial resistance: A detailed account of a successful public engagement event. FEMS Microbiol. Lett. 2018, 365, fny175. [Google Scholar] [CrossRef]
- Bloomfield, S.F. Rsph and ifh call for a clean-up of public understanding and attitudes to hygiene. Perspect. Public Health 2019, 139, 285–288. [Google Scholar] [CrossRef]
- Rook, G.A.W. 99th dahlem conference on infection, inflammation and chronic inflammatory disorders: Darwinian medicine and the ‘hygiene’ or ‘old friends’ hypothesis. Clin. Exp. Immunol. 2010, 160, 70–79. [Google Scholar] [CrossRef] [PubMed]
- Lamfon, H.; Al-Karaawi, Z.; McCullough, M.; Porter, S.R.; Pratten, J. Composition of in vitro denture plaque biofilms and susceptibility to antifungals. FEMS Microbiol. Lett. 2005, 242, 345–351. [Google Scholar] [CrossRef] [PubMed]
- Marsh, P.D.; Zaura, E. Dental biofilm: Ecological interactions in health and disease. J. Clin. Periodontol. 2017, 44, S12–S22. [Google Scholar] [CrossRef] [PubMed]
- Penick, C. Power toothbrushes: A critical review. Int. J. Dent. Hyg. 2004, 2, 40–44. [Google Scholar] [CrossRef] [PubMed]
- Bartlett, D.W.; Smith, B.G.; Wilson, R.F. Comparison of the effect of fluoride and non-fluoride toothpaste on tooth wear in vitro and the influence of enamel fluoride concentration and hardness of enamel. Br. Dent. J. 1994, 176, 346–348. [Google Scholar] [CrossRef] [PubMed]
- Prasanth, M. Antimicrobial efficacy of different toothpastes and mouthrinses: An in vitro study. Dent. Res. J. 2011, 8, 85–94. [Google Scholar]
- Marlow, V.L.; MacLean, T.; Brown, H.; Kiley, T.B.; Stanley-Wall, N.R. Blast a biofilm: A hands-on activity for school children and members of the public. J. Microbiol. Biol. Educ. 2013, 14, 252–254. [Google Scholar] [CrossRef][Green Version]
- Redfern, J.; Burdass, D.; Verran, J. Transforming a school learning exercise into a public engagement event: "The good, the bad and the algae". J. Biol. Educ. 2013, 47, 246–252. [Google Scholar] [CrossRef]
- Verran, J.; Redfern, J.; Moravej, H.; Adebola, Y. Refreshing the public appetite for ‘good bacteria’: Menus made by microbes. J. Biol. Educ. 2018, 53, 34–46. [Google Scholar] [CrossRef]
- Cohen, L.; Manion, L.; Morrison, K. Research Methods in Education, 7th ed.; Routledge: Oxon, UK, 2011. [Google Scholar]
- Caballero, L.; Whitehead, K.A.; Allen, N.S.; Verran, J. Photoinactivation of Escherichia coli on acrylic paint formulations using fluorescent light. Dyes Pigment. 2010, 86, 56–62. [Google Scholar] [CrossRef]
- Carp, O.; Huisman, C.L.; Reller, A. Photoinduced reactivity of titanium dioxide. Prog. Solid State Chem. 2004, 32, 33–177. [Google Scholar] [CrossRef]
- Chen, J.; Poon, C.-S. Photocatalytic construction and building materials: From fundamentals to applications. Build. Environ. 2009, 44, 1899–1906. [Google Scholar] [CrossRef]
- Smits, M.; Huygh, D.; Craeye, B.; Lenaerts, S. Effect of process parameters on the photocatalytic soot degradation on self-cleaning cementitious materials. Catal. Today 2014, 230, 250–255. [Google Scholar] [CrossRef]
- Hanley, S. Secrets of the Sydney Opera House. Available online: https://greenbuildingelements.com/2017/01/30/secrets-sydney-opera-house/ (accessed on 3 October 2019).
- Stewart, P.S.; William Costerton, J. Antibiotic resistance of bacteria in biofilms. Lancet 2001, 358, 135–138. [Google Scholar] [CrossRef]
- O’Neill, J. Tackling Drug-Resistant Infections Globally: Final Report and Recommendations; Resistance, R.O.A., Ed.; Wellcome Trust: London, UK, 2016. [Google Scholar]

| General Considerations | Example | |
|---|---|---|
| Event | Audience, venue, time, date, numbers | Adults, evening, 3 hours, audience around 500 participants, drop-in marketplace format |
| Topic | Theme | AMR and biofilms |
| Aim/hypothesis | Aim: To engage the audience with the biofilm phenomenon and its relationship with AMR Hypothesis: That the audience will leave the event with an increased awareness of AMR and some knowledge of biofilms | |
| The message | What specific message(s) | About AMR What biofilms are Why biofilms are important with regard to AMR |
| What will be happening | Focus activities on key messages, encourage active participation and engagement | Welcome table (guide to activities) Bitesize quotes about AMR on a pop-up stand iPad questionnaire used to lead discussion about AMR Screening of the film ‘Catch’ [4] Swabbing face/nasal area (anonymous) Rolling images of biofilm Discussion about biofilm Building biofilm using Bunch’ems (www.bunchems.com) Sign up to Antibiotic Guardians (www.antibioticguardian.com) |
| Personnel required | Ensure sufficient numbers of staff/students, all familiar with overall aims and activities and informed about key messages | Welcome table: one person; AMR discussion: 2–3 people What is AMR [27]? Why is it important? Swabbing table: 2–3 people Biofilm discussion and activity: 3–4 people What is a biofilm? How common are they/where are they? What do they look like? Why is AMR important in biofilms?
Floating support staff: 2 people Observers: 2 people [8] Estimate 12 personnel required |
| Evaluation | Quantitative and qualitative assessment regarding achievement of aims | Survey of ‘do you know what a biofilm is?’ (yes/no) Survey of understanding/information about AMR Number of agar plates used Number of visitors to Flickr (presenting images of plates post-incubation) Qualitative observation of discussion/questions/activities Photographs/images of biofilms being built/Twitter hashtag usage #buildabiofilm Number of Antibiotic Guardian sign-ups/leaflets taken |
| Actions | Preparation in advance of the event | Health and safety documents/risk assessment List of staff/volunteers’ names Ethical approval for survey, agar plates/swabs and observers Produce pop-up Develop yes/no test for prior knowledge of biofilms Provide substrata/backdrop for Bunch’ems (e.g., giant microscope slides, other surfaces) Practice building biofilms Produce biofilm slideshow Develop Q&A for iPad Identify key messages and provide them to the team (laminated) Sheet for observers Antibiotic Guardian information |
| Logistics | Arrival time and set up Staff rota Refreshments Transport of agar plates and other equipment Briefing pre-event, with key messages Debriefing post-event, fix date/time |
© 2020 by the authors. Licensee MDPI, Basel, Switzerland. This article is an open access article distributed under the terms and conditions of the Creative Commons Attribution (CC BY) license (http://creativecommons.org/licenses/by/4.0/).
Share and Cite
Verran, J.; Jackson, S.; Scimone, A.; Kelly, P.; Redfern, J. Biofilm Control Strategies: Engaging with the Public. Antibiotics 2020, 9, 465. https://doi.org/10.3390/antibiotics9080465
Verran J, Jackson S, Scimone A, Kelly P, Redfern J. Biofilm Control Strategies: Engaging with the Public. Antibiotics. 2020; 9(8):465. https://doi.org/10.3390/antibiotics9080465
Chicago/Turabian StyleVerran, Joanna, Sarah Jackson, Antony Scimone, Peter Kelly, and James Redfern. 2020. "Biofilm Control Strategies: Engaging with the Public" Antibiotics 9, no. 8: 465. https://doi.org/10.3390/antibiotics9080465
APA StyleVerran, J., Jackson, S., Scimone, A., Kelly, P., & Redfern, J. (2020). Biofilm Control Strategies: Engaging with the Public. Antibiotics, 9(8), 465. https://doi.org/10.3390/antibiotics9080465

